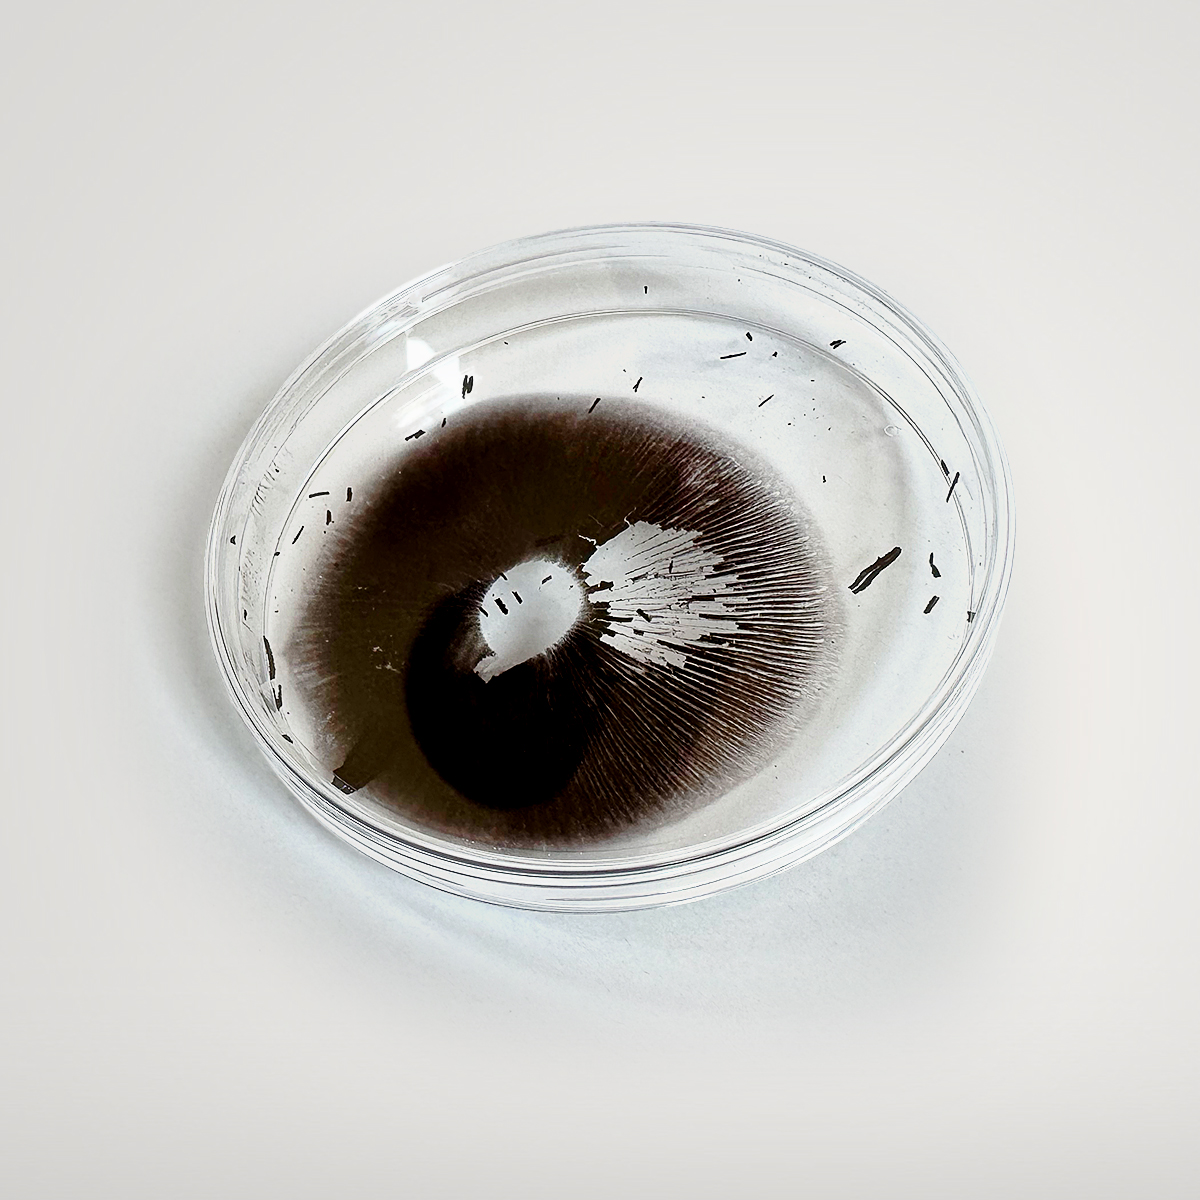

Description
Growing from spore prints is perhaps the most basic way to obtain mushrooms. It’s the most difficult, takes the longest, and because of the long time and numerous steps required to grow even one mushroom, it’s also the most susceptible to contamination. However, it is the most enjoyable and educational way to grow mushrooms. You do everything from A to Z. With one spore print, you can grow your own mushrooms for years, and eventually, your own spore prints. They’re fun to give away to friends, or sell them and recoup your investment. Available in many mushroom varieties
| Gewicht | 20 g |
|---|---|
| Größe | 95 × 95 × 15 mm |